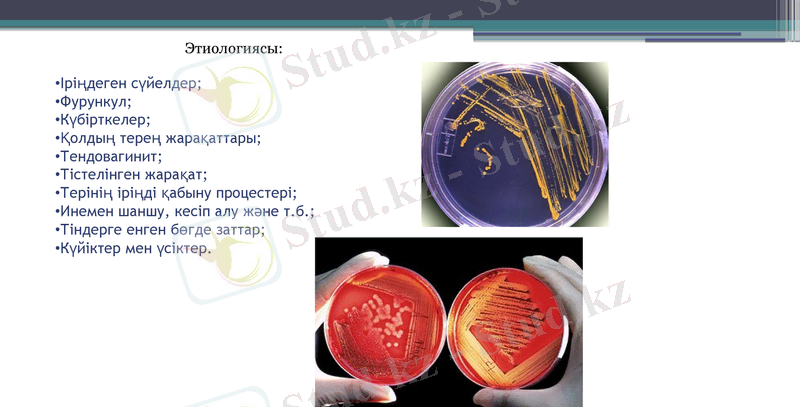
Slide 3

Қол ұшы флегмоналары: жіктелуі, клиникалық көрінісі және емдеу тактикасы



Қазақстан-Ресей Медициналық Университеті
Госпитальды хирургия
Қол ұшы флегмоналары
Орындаған: Абат А.
Қабылдаған: Жапбаркулова Г. Р.
Алматы 2020ж.

Флегмона деп май клечаткасының жедел іріңді түрде қабынуын айтады. Абсцесспен салыстырғанда айқын шекаралары болмайды.
Іріңдеген сүйелдер;
Фурункул;
Күбірткелер;
Қолдың терең жарақаттары;
Тендовагинит;
Тістелінген жарақат;
Терінің іріңді қабыну процестері;
Инемен шаншу, кесіп алу және т. б. ;
Тіндерге енген бөгде заттар;
Күйіктер мен үсіктер.
Этиологиясы:

Қол ұшы флегмоналары :
1. Тенардың бұлшықетаралық флегмонасы.
2. Гипотенардың бұлшықетаралық флегмонасы.
3. Комиссуральді флегмона (мозольді абсцесс, намин) .
4. Орталық алақан кеңістігінің флегмонасы (сіңір үстілік жəне астылық, апоневроз асты жəне үсті) .
5. Тоғысқан /U-тəрізді/ флегмона.
6. Саусақ сыртының теріасты (апоневрозүсті) флегмонасы.
7. Саусақ сыртының апоневрозасты флегмонасы.
8. Саусақ сыртының фурункулы (карбункул) .
Жіктелуі

Саусақаралық (комиссуральді) флегмона

Тенар аймағындағы флегмона

Гипотенар аймағындағы флегмона

Тоғысқан /U-тəрізді/ флегмона


Синовиальді қапшық флегмонасы

Клиникалық көрінісі процестің тез пайда болып таралуымен сипатталады. Науқаста жалпы және жергілікті көріністер орын алады. Жалпы белгілеріне: дене температурасының жоғарылауы, жалпы мазасыздану жатады.

Жергілікті белгілері:
• ruber (қызару),
• color (жергілікті температураның жоғарылауы),
• tumor (домбығу),
• dolor (ауырсыну),
• functio laesa (қызметінің бұзылуы) .

Негізгі жəне қосымша диагностикалық шаралар тізімі:
1. Қанның жалпы анализі.
2. Зəрдің жалпы анализі.
3. Флораны анықтау жəне оның антибиотиктерге сезімталдылығын анықтау.
4. Қан тобы мен резус факторды анықтау.
5. Дифенил сынамасын, тимолсынамасын, глюкозаны анықтау.
6. АЛТ анықтау.
7. ЭКГ.
8. Өкпе рентгенографиясы.
9. Глист жұмыртқасына нəжісті зерттеу.
10. Қандағы қантты зерттеу.
11. Эндокринолог консультациясы.
12. HBs Ag, anti - HCV ВИЧ.

Флюктуация симптомын тексеру

Ем мақсаты: оперативті ем жəне іріңді ошақтарды санациялау, тері жабындыларының жəне қолдың функциясын қалпына келтіру, рецидивтің алдын алу.
Дəрі дəрмексіз ем: қабынудың серозды-инфильтративті фазасында спирттік ванналар, трипсин, химотрипсин электрофорезі, антибиотикотерапия қолданылады, оның ішінде антибиотиктерді регионарлық венаішілік енгізу, УВЧ-терапия.
Дəрі дəрмектік ем: операциядан кейін микрофлора сезімталдылығы ескеріліп, антибиотикотерапия қолданылады, антисептиктер, сульфаниламидтер, протеолиздік ферменттер, физио- жəне рентгенотерапия.

Тері некрозында жəне шекаралық (демаркациялық) сызықтар пайда болғанда некрэктомия жүргізеді. Жараны некроздық массалардан жəне іріңнен тазалағаннан кейін жақпа маймен таңғыш салады. Емдеу барысында физиотерапиялық шаралар жүргізіледі (УФО, УВЧ жəне т. б. ), сонымен қатар түйіршіктердің өсуі мен эпителиленуі консервіленген плацента, фибринді пленка, жараны ультрадыбыспен, лазер сəулесімен өңдеу арқылы жүзеге асырылады.
Жергілікті еммен параллель интенсивті ем жүргізіледі, оның құрамында дезинтоксикациялық, антибактериялық жəне иммуностимулдеуші шаралар болуы тиіс. Жаңа туылған нəрестелерде флегмонаның болжамы əрқашан ауыр болады. Диагноз неғұрлым ерте қойылып емдеу шаралары ерте басталса, соғұрлым аурудың болжамы жақсы болу мүмкіндігі жоғары болады.

Саусақ сыртындағы флегмонаны (беткейлік жəне терең) ұзынша сызықпен айқын флюктуация жəне гиперемия жерінде ашады. Осындай əдіспен алақан жəне үстіңгі жақ абсцесстері ашылады.
Ортаңғы алақан кеңістігінің беткейлік флегмонасын ұзынша кесіп, саусақтың алақан бетіндегі некроздалған апоневрозды кеседі.
Ортаңғы алақан кеңістігінің терең флегмонасын осындай əдіспен кеседі. Алақандық апоневрозды кескеннен кейін емшараны алақандық артериалдық доғаны зақымдап алмас үшін, тұйық жолмен жүргізеді.
Фасциальді май қабат кеңістігінің флегмонасын линиялық тілікпен кесіп, əрі қарай жараны дренаждайды. Тенар флегмонасын ашу кезде орталық нервті зақымдап алмау қажет.
Комиссуральді флегмонаны тиісті сүйекаралықта линиялық тілікпен кеседі. Саусақтың бүйірлік бетінде қабыну процессінің таралуында іріңді қосымша тіліктен дренаждайды.

Алақанның флегмоналары кезінде кесу жүргізу:
а -тенар және алақанның ортаңғы кеңістігінің флегмонасы: 1 -Iselin бойынша кесу, 2 - Канавел юойынша кесу, 3, 4 - Войно-Ясенецкий бойынша; б - алақанның ортаңғы кеңістігінің флегмонасы: 1 -Iselin бойынша кесу, 2 - Пик бойынша кесу (кеңістік пунктирмен белгіленген) ; в - Канавел бойынша кесу

Саусақаралық флегмонаны дренирлеу әдісі

- Іс жүргізу
- Автоматтандыру, Техника
- Алғашқы әскери дайындық
- Астрономия
- Ауыл шаруашылығы
- Банк ісі
- Бизнесті бағалау
- Биология
- Бухгалтерлік іс
- Валеология
- Ветеринария
- География
- Геология, Геофизика, Геодезия
- Дін
- Ет, сүт, шарап өнімдері
- Жалпы тарих
- Жер кадастрі, Жылжымайтын мүлік
- Журналистика
- Информатика
- Кеден ісі
- Маркетинг
- Математика, Геометрия
- Медицина
- Мемлекеттік басқару
- Менеджмент
- Мұнай, Газ
- Мұрағат ісі
- Мәдениеттану
- ОБЖ (Основы безопасности жизнедеятельности)
- Педагогика
- Полиграфия
- Психология
- Салық
- Саясаттану
- Сақтандыру
- Сертификаттау, стандарттау
- Социология, Демография
- Спорт
- Статистика
- Тілтану, Филология
- Тарихи тұлғалар
- Тау-кен ісі
- Транспорт
- Туризм
- Физика
- Философия
- Халықаралық қатынастар
- Химия
- Экология, Қоршаған ортаны қорғау
- Экономика
- Экономикалық география
- Электротехника
- Қазақстан тарихы
- Қаржы
- Құрылыс
- Құқық, Криминалистика
- Әдебиет
- Өнер, музыка
- Өнеркәсіп, Өндіріс
Қазақ тілінде жазылған рефераттар, курстық жұмыстар, дипломдық жұмыстар бойынша біздің қор #1 болып табылады.



Ақпарат
Қосымша
Email: info@stud.kz